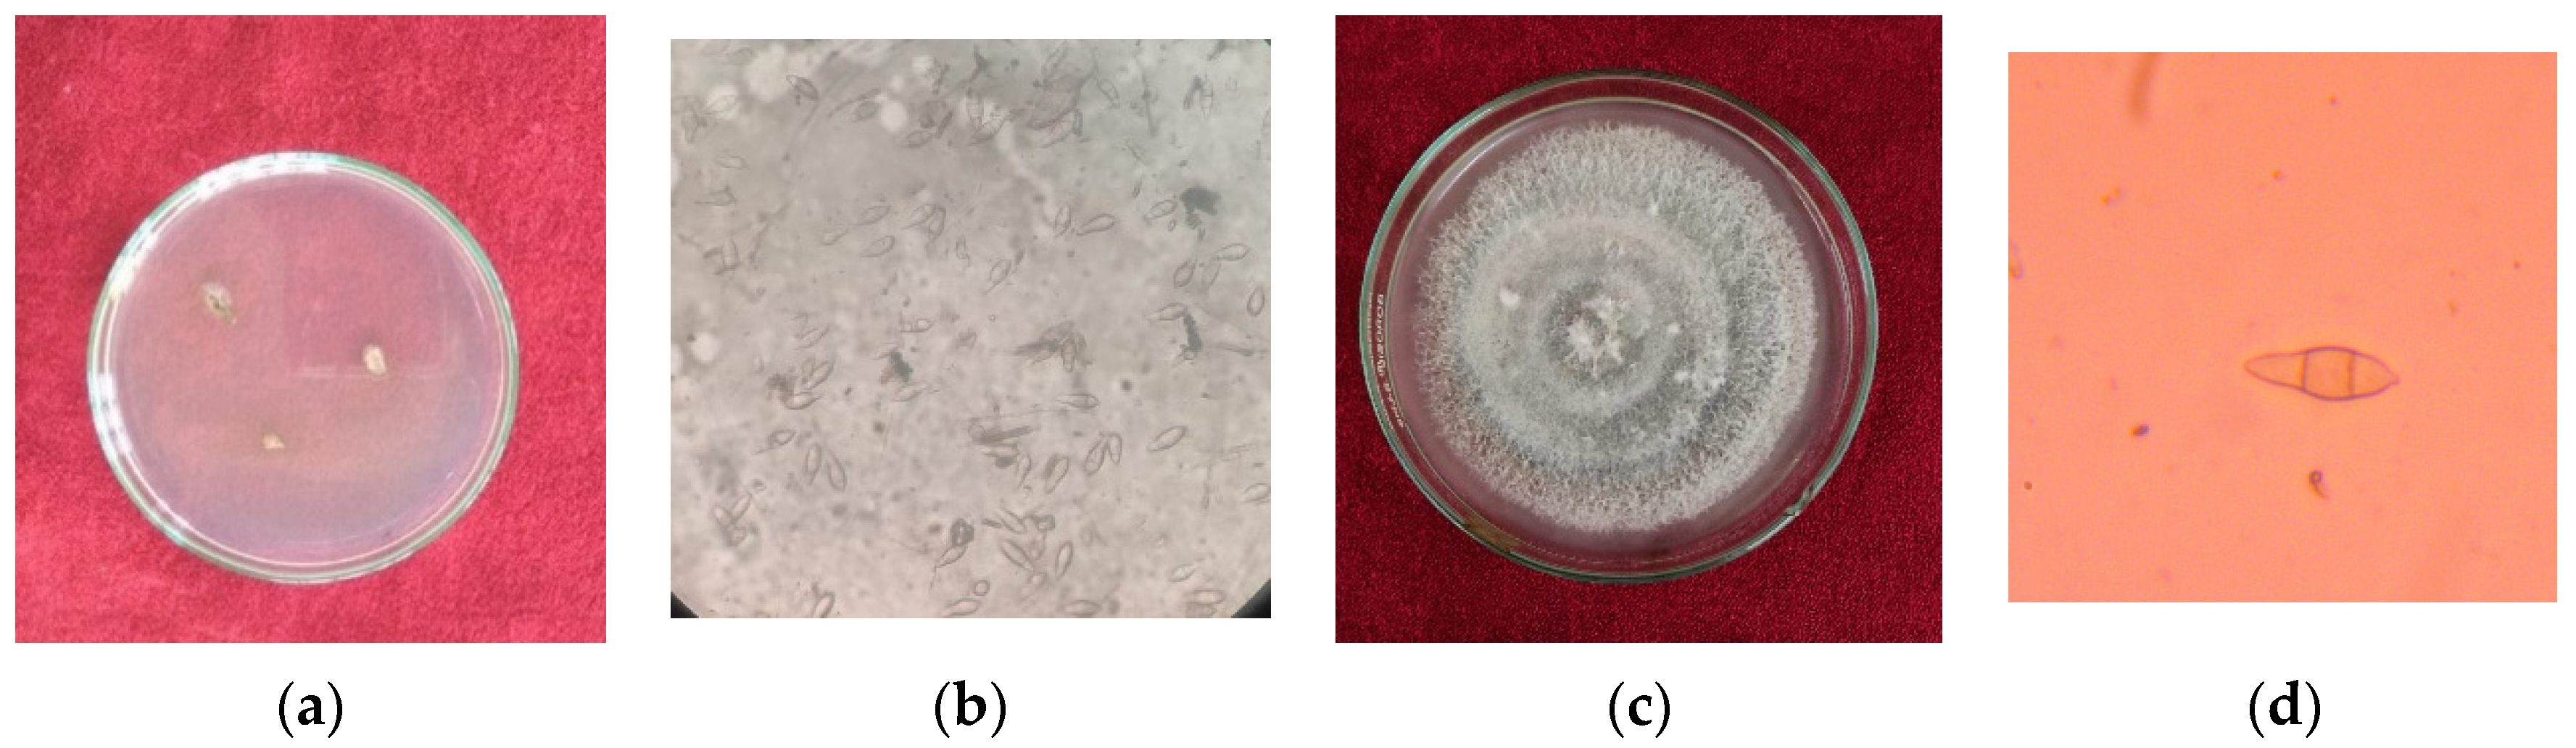
Jof 07 01060 g002 Jof 07 01060 g002

Combination of Strobilurin and Triazole Chemicals for the Management of Blast Disease in Mushk Budji -Aromatic Rice
Abstract
1. Introduction
2. Materials and Methods
2.1. Characterization of Blast Pathogen
2.1.1. Isolation
2.1.2. Morphological Characteristics
2.1.3. Field Experiments
2.2. Statistical Analysis
3. Results
3.1. Effect of Fungicide Treatments on Leaf Blast Incidence
3.2. Effect of Fungicide Treatments on Leaf Blast Severity
3.3. Effect of Fungicide Treatments on Neck Blast Incidence
3.4. Effect of Fungicide Treatments on Yield
4. Discussion
5. Conclusions
Author Contributions
Funding
Institutional Review Board Statement
Informed Consent Statement
Data Availability Statement
Acknowledgments
Conflicts of Interest
References
- Spence, C.; Alff, E.; Johnson, C.; Ramos, C.; Donofrio, N.; Sundaresan, V.; Bais, H. Natural rice rhizospheric microbes suppress rice blast infections. BMC Plant Biol. 2014, 14, 130. [Google Scholar] [CrossRef] [PubMed]
- Hayasaka, T.; Fujii, H.; Ishiguro, K. The role of silicon in preventing appressorial penetration by the rice blast fungus. Phytopathology 2008, 98, 1038–1044. [Google Scholar] [CrossRef] [PubMed][Green Version]
- Pachauri, V.; Singh, M.K.; Singh, A.K.; Singh, S.; Shakeel, N.A.; Singh, V.P.; Singh, N.K. Origin and genetic diversity of aromatic rice varieties, molecular breeding and chemical and genetic basis of rice aroma. J. Plant Biochem. Biotechnol. 2010, 19, 127–143. [Google Scholar] [CrossRef]
- Wang, X.; Jia, M.; Ghai, P.; Lee, F.; Jia, Y. Genome-wide association of rice blast disease resistance and yield-related components of rice. Mol. Plant-Microbe Interact. 2015, 28, 1383–1392. [Google Scholar] [CrossRef]
- Sharma, T.R. Rice blast management through host-plant resistance: Retrospect and prospects. Agric. Res. 2012, 1, 37–52. [Google Scholar] [CrossRef]
- Zeigler, R.S.; Leong, S.A.; Teng, P.S. Rice Blast Disease; CAB International: Wallingford, UK, 1994. [Google Scholar]
- Nalley, L.; Tsiboe, F.; Durand-Morat, A.; Shew, A.; Thoma, G. Economic and environmental impact of rice blast pathogen (Magnaporthe oryzae) alleviation in the United States. PLoS ONE 2016, 11, e0167295. [Google Scholar]
- Katsantonis, D.; Koutroubas, S.D.; Ntanos, D.A.; Lupotto, E. A comparison of three experimental designs for the field assessment of resistance to rice blast disease (Pyricularia oryzae). J. Phytopathol. 2007, 155, 204–210. [Google Scholar] [CrossRef]
- Mbodi, Y.; Gaye, S.; Diaw, S. The role of tricyclazole in rice protection against blast and cultivar improvement. Parasitica 1987, 43, 187–198. [Google Scholar]
- Moletti, M.; Giudici, M.L.; Nipoti, E.; Villa, B. Chemical control trials against rice blast in Italy. Inform. Fitopatol. 1988, 38, 41–47. [Google Scholar]
- Georgopoulos, S.G.; Ziogas, B.N. Principles and Methods for Control of Plant Diseases; Athens, Greece, 1992; 236p. [Google Scholar]
- Naidu, V.D.; Reddy, G.V. Control of blast (BI) in main field and nursery with some new fungicides. Rev. Palaeobot. Palynol. 1989, 69, 209. [Google Scholar]
- Bonman, J.M.; Khush, G.S.; Nelson, R.J. Breeding rice for resistance to pests. Annu. Rev. Phytopathol. 1992, 30, 507–528. [Google Scholar] [CrossRef]
- Chuma, I.; Isobe, C.; Hotta, Y.; Ibaragi, K.; Futamata, N.; Kusaba, M.; Yoshida, K.; Terauchi, R.; Fujita, Y.; Nakayashiki, H.; et al. Multiple translocation of the AVR-Pita effector gene among chromosomes of the rice blast fungus Magnaporthe oryzae and related species. PLoS Pathog. 2011, 7, e1002147. [Google Scholar] [CrossRef] [PubMed]
- Skamnioti, P.; Gurr, S.J. Against the grain: Safeguarding rice from rice blast disease. Trends Biotechnol. 2009, 27, 141–150. [Google Scholar] [CrossRef]
- Manandhar, H.K. Seed treatment against rice leaf blast. Nepal J. Agric. 1984, 15, 189. [Google Scholar]
- Chaudhary, B.; Sah, D.N. Efficacy of Beam 75 WP in controlling leaf blast disease at the seedling stage of rice. Nepal Agric. Res. J. 1998, 2, 42–47. [Google Scholar]
- Manandhar, H.K.; Thapa, B.J.; Amatya, P. Efficacy of various fungicides on the control of rice blast disease. J. Inst. Agric. Anim. Sci. 1985, 6, 21–29. [Google Scholar]
- Sah, D.N.; Karki, P.B. Efficacy of seed treatment and crop management in controlling leaf blast disease of rice. In Proceedings of the Rice Technical Working Group Meeting, Parwanipur, Nepal, 6–8 March 1988. [Google Scholar]
- Chaudhary, B. Effect of blast disease on rice yield. Nepal Agric. Res. J. 1999, 3, 8–13. [Google Scholar]
- Kumar, S.; Kashyap, P.L.; Mahapatra, S.; Jasrotia, P.; Singh, G.P. New and emerging technologies for detecting Magnaporthe oryzae causing blast disease in crop plants. Crop Prot. 2021, 143, 105473. [Google Scholar] [CrossRef]
- Chou, C.; Castilla, N.; Hadi, B.; Tanaka, T.; Chiba, S.; Sato, I. Rice blast management in Cambodian rice fields using Trichoderma harzianum and a resistant variety. Crop Prot. 2020, 135, 104864. [Google Scholar] [CrossRef]
- Mariappan, V.; Rajeswari, E.; Kamalakannan, A. Management of rice blast, Pyricularia oryzae by using neem (Azadirachta indica) amd other plant products. In Neem for the Management of Crop Diseases; Mariappan, V., Ed.; Associated Publishing Co.: New Delhi, India, 1995; pp. 3–10. [Google Scholar]
- Dutta, D.; Saha, S.; Ray, D.P.; Bag, M.K. Effect of different active fungicides molecules on the management of rice blast disease. Int. J. Agric. Environ. Biotechnol. 2012, 5, 247–251. [Google Scholar]
- Kumar, M.K.P.; Gowda, D.K.S.; Moudgal, R.; Kumar, N.K.; Gowda, K.T.P.; Vishwanath, K. Impact on fungicides on rice production in India. In Fungicides-Showcases of Integrated Plant Disease Management from around the World; Nita, M., Ed.; inTech: Nappanee, IN, USA, 2013; ISBN 978-953-51-1130-6. Available online: http://www.intechopen.com/books/fungicides-showcases-of-integrated-plant-disease-management-from-around-the-world/impact-of-fungicides-on-rice-production-in-india (accessed on 7 October 2021). [CrossRef]
- Swamy, H.N.; Sannaulla, S.; Kumar, M.D. Evaluation of new fungicides against rice blast in cauvery delta. Karnataka J. Agric. Sci. 2009, 22, 450–451. [Google Scholar]
- Kongcharoen, N.; Kaewsalong, N.; Dethoup, T. Efficacy of fungicides in controlling rice blast and dirty panicle diseases in Thailand. Sci. Rep. 2020, 10, 16233. [Google Scholar] [CrossRef] [PubMed]
- Anonymous. Nohyaku-Yoran (Statistics of Agro-Chemicals in Japan); Japan Plant Protection Association: Tokyo, Japan, 1992. [Google Scholar]
- Filippi, M.C.; Prabhu, A.S. Integrated effect of host plant resistance and fungicidal seed treatment on rice blast control in Brazil. Plant Dis. 1997, 81, 351–355. [Google Scholar] [CrossRef] [PubMed][Green Version]
- Motoyama, T.; Nakasako, M.; Yamaguchi, I.; Lyr, H.; Russell, P.E.; Dehne, H.W.; Sisler, H.D. Molecular action mechanism of a new melanin biosynthesis inhibitor. In Modern Fungicides and Antifungal Compounds II. 12th International Reinhardsbrunn Symposium, Thuringia, Germany, 24–29 May 1998; Intercept Ltd.: Curepipe, Mauritius, 1999; pp. 111–119. [Google Scholar]
- Lee, F.N.; Beaty, T. Evaluation of foliar fungicides for control of neck blast of rice. F&N Tests 1999, 55, 329. [Google Scholar]
- Tangdiabang, J.; Pakki, S. Penyakit blast (Pyricularia grisea) dan strategi pengendaliannya pada tanaman padi. Pus. Penelit. Tanam. Pangan Dep. Pertan. 2006, 7, 241–245. [Google Scholar]
- Sicard, D.; Michalakis, Y.; Dron, M.; Neema, C. Genetics diversity and pathogenic variation of Colletotrichum lindemuthianum in three centers of diversity of its host, Phaseolus vulgaris. Phytopathology 1997, 87, 807–813. [Google Scholar] [CrossRef]
- Asfaha, M.G.; Selvaraj, T.; Woldeab, G. Assessment of disease intensity and isolates characterization of blast disease (Pyricularia oryzae CAV.) from South West of Ethiopia. Int. J. Life Sci. 2015, 3, 271–286. [Google Scholar]
- Mew, T.W.; Gonzales, P.A. Handbook of Rice Seed Borne Fungi; International Rice Research Institute: Los Banos, Philippines, 2002; p. 83. [Google Scholar]
- Meena, B.S. Morphological and Molecular Variability of Rice Blast Pathogen, Pyricularia Grisea (Cooke) Sacc; Mew, T.W.G., Ed.; Department of Plant Pathology, College of Agriculture, Dharwad University of Agricultural Sciences: Dharwad, India, 2005; pp. 12–54. [Google Scholar]
- Anonymous. Standard Evaluation System for Rice, 5th ed.; IRRI: Los Banos, CA, USA, 2013. [Google Scholar]
- Madden, L.V.; Hughes, G.; Bosch, F. The Study of Plant Disease Epidemics; APS: St. Paul, MN, USA, 2007; pp. 145–171. [Google Scholar]
- Seebold, K.W.; Datnof, J.L.E.; Correa-Victoria, F.J.; Kucharek, T.A.; Suyder, G.H. Effects of silicon and fungicides on the control of leaf and neck blast in Upland rice. Plant Dis. 2004, 88, 253–258. [Google Scholar] [CrossRef][Green Version]
- Pak, D.; You, M.P.; Lanoiselet, V.; Barbetti, M.J. Azoxystrobin and propiconazole offer significant potential for rice blast (Pyricularia oryzae) management in Australia. Eur. J. Plant Pathol. 2017, 148, 247–259. [Google Scholar] [CrossRef]
- Pramesh, D.; Nataraj, K.; Guruprasad, G.S.; Mahantashivayogayya, K.; Reddy, B.G.M. Evaluation of a new strobilurin group of fungicide for the management of blast disease of paddy. Am. J. Exp. Agric. 2016, 13, 1–6. [Google Scholar] [CrossRef]
- Magar, P.B.; Acharya, B.; Pandey, B. Use of chemical fungicides for the management of rice blast (Pyricularia grisea) disease at Jyotinagar, Chitwan, Nepal. IJASBT 2015, 3, 474–478. [Google Scholar] [CrossRef]
- Sood, G.K.; Kapoor, A.S. Efficacy of new fungicides in the management of rice blast. Plant Dis. Res. 1997, 12, 140–142. [Google Scholar]
- Ganesh, N.R.; Gangadhara, N.B.; Basavaraja, N.T.; Krishna, N.R. Fungicidal management of leaf blast disease in rice. J. Bio-Sci. Biotechnol. 2012, 1, 18–21. [Google Scholar]
- Pal, R.; Mandal, D.; Naik, B.S. Effect of different meteorological parameters on the development and progression of rice leaf blast disease in western Odisha. Int. J. Plant Prot. 2017, 10, 52–57. [Google Scholar] [CrossRef]
- Pradhan, J.; Baliarsingh, A.; Biswal, G.; Das, M.P.; Pasupalak, S. Effect of Weather Parameters on Infestation of Blast Disease (Pyricularia oryzae) in Rabi Season Rice (Oryza sativa L.) in East & South Eastern Coastal Plain of Odisha. Int. J. Curr. Microbiol. Appl. Sci. 2018, 7, 893–900. [Google Scholar]
- Wheeler, M.H. Melanin biosynthesis in Verticillium daliae: Dehydratation and reduction reactions in cell-free homogenates. Exp. Mycol. 1982, 6, 171–179. [Google Scholar] [CrossRef]
- Raj, R.; Pannu, P.P.S. Management of rice blast with different fungicides and potassium silicate under in vitro and in vivo conditions. J. Plant Pathol. 2017, 99, 707–712. [Google Scholar]
- Bag, M.K.; Saha, S. Fungitoxic effect of nativo 75 WG (trifloxystrobin 25% + tebuconazole 50%) on grain discoloration (GD) disease of rice in West Bengal. Pestology 2009, 33, 47–49. [Google Scholar]
- Biswas, A.; Bag, M.K. Strobilurins in management of sheath blight disease of rice: A review. Pestology 2010, 34, 23–26. [Google Scholar]
- Bhuvaneswari, V.; Raju, K.S. Efficacy of new combination fungicide against rice sheath blight caused by Rhizoctonia solani (Kuhn). J. Rice Res. 2012, 5, 57–59. [Google Scholar]
- Chen, Y.; Yao, J.; Wang, W.; Gao, T.; Yang, X.; Zhang, A. Effect of epoxiconazole on rice blast and rice grain yield in China. Eur. J. Plant Pathol. 2013, 135, 675–682. [Google Scholar] [CrossRef]
- Kramar, W.; Schirmer, U. Modern Crop Protection Compounds, V-II: Fungicides, 3rd ed.; Wiley: Weinheim, Germany, 2007. [Google Scholar]
- Pandey, S. Effect of fungicides on leaf blast and grain yield of rice in Kymore region of Madhya Pradesh in India. Bangladesh J. Bot. 2016, 45, 353–359. [Google Scholar]

| Category | Symptoms |
|---|---|
| 0 | No lesion |
| 1 | Small brown specks of pinhead size without sporulating center |
| 2 | Small roundish to slightly elongated, necrotic grey spots, about 1–2 mm in diameter with a distinct brown margin and lesions are mostly found on the lower leaves |
| 3 | Lesion type is the same as in scale 2, but significant number of lesions are on the upper leaves |
| 4 | Typical sporulating blast lesions, 3 mm of longer, infecting less than 2% of the leaf area |
| 5 | Typical blast lesions infecting 2–10% of the leaf area |
| 6 | Blast lesions infecting 11–25% leaf area |
| 7 | Blast lesions infecting 26–50% leaf area |
| 8 | Blast lesions infecting 51–75% leaf area |
| 9 | More than 75% of leaf area affected |
| Active Ingredient | Fungicide | Chemical Group | Concentration per Liter of Water | Leaf Blast Incidence | Neck Blast Incidence | Leaf Blast Severity |
|---|---|---|---|---|---|---|
| Flusilazole 12.5% + Carbendazim 25% SC | Lustre | triazole plus benzimidazoles | 1 mL | 21.88 ± 0.69 b | 35.27 ± 0.76 c | 7.45 ± 0.56 c |
| Azoxystrobin 18.2% + difenconazole 11.4% SC | Amistar® Top | triazole plus strobilurin | 1 mL | 8.97 ± 0.71 e | 12.56 ± 0.40 i | 2.53 ± 0.55 g |
| Azoxystrobin 11% + tebuconazole 18.3% SC | Custodia | triazole plus strobilurin | 1.5 mL | 9.57 ± 0.57 e | 15.52 ± 1.25 h | 3.00 ± 0.20 f,g |
| Tricyclazole 18% + mancozeb 62% WP | Merger | triazole plus dithiocarbamate | 2.5 g | 11.67 ± 0.64 d | 18.8 ± 0.54 g | 3.89 ± 0.35 e,f |
| Zineb 68% + hexaconazole 4% | Avatar | triazole plus dithiocarbamate | 2.5 g | 17.09 ± 0.56 c | 28.12 ± 0.76 e | 6.21 ± 0.46 d |
| Trifloxystrobin 25% + tebuconazole 50% WG | Nativo® | triazole plus strobilurin | 0.4 g | 11.54 ± 0.53 d | 20.19 ± 0.80 f | 4.89 ± 0.23 e |
| Mancozeb 50% + Carbendazim 25% WS | Sprint® | dithiocarbamate plus benzimidazole | 2.5 g | 12.3 ± 0.96 d | 36.55 ± 0.68 b | 10.05 ± 1.07 b |
| Fluxapyroxad 62.5 g/L + epoxiconazole 62.5 g/L EC | Adexar® | pyrazole-carboximide plus triazole | 1.5 mL | 22.57 ± 1.54 b | 30.83 ± 0.72 d | 7.61 ± 0.45 c |
| Tricyclazole 75% | Force 11TM | melanin biosynthesis inhibitors—reductase | 0.6 g | 6.86 ± 0.90 f | 12.22 ± 0.35 i | 2.95 ± 0.10 f,g |
| Water (Control) | - | - | - | 64.92 ± 0.52 a | 87.50 ± 1.47 a | 26.24 ± 1.13 a |
| Active Ingredient | Fungicide | Chemical Group | Concentration per Liter of Water | Leaf Blast Incidence | Neck Blast Incidence | Leaf Blast Severity |
|---|---|---|---|---|---|---|
| Flusilazole 12.5% + carbendazim 25% SC | Lustre | triazole plus benzimidazoles | 1 mL | 22.64 ± 0.94 c,b | 36.23 ± 1.50 b | 8.76 ± 0.80 c |
| Azoxystrobin 18.2% + difenconazole 11.4% SC | Amistar® Top | triazole plus strobilurin | 1 mL | 9.19 ± 1.35 f | 14.74 ± 2.21 f | 3.43 ± 0.46 f |
| Azoxystrobin 11% + tebuconazole 18.3% SC | Custodia | triazole plus strobilurin | 1.5 mL | 10.40 ± 0.60 e,f | 16.64 ± 0.97 f | 3.82 ± 0.27 e,f |
| Tricyclazole 18% + mancozeb 62% WP | Merger | triazole plus dithiocarbamate | 2.5 g | 12.49 ± 0.50 e | 20.01 ± 0.74 e | 4.93 ± 0.20 e |
| Zineb 68% + hexaconazole 4% | Avatar | triazole plus dithiocarbamate | 2.5 g | 18.61 ± 1.11 d | 29.51 ± 1.34 d | 6.72 ± 0.42 d |
| Trifloxystrobin 25% + tebuconazole 50% WG | Nativo® | triazole plus strobilurin | 0.4 g | 12.43 ± 0.56 e | 19.92 ± 0.86 e | 4.68 ± 0.87 e,f |
| Mancozeb 50% + Carbendazim 25% WS | Sprint® | dithiocarbamate plus benzimidazole | 2.5 g | 27.61 ± 0.75 b | 38.31 ± 1.36 b | 10.78 ± 0.58 b |
| Fluxapyroxad 62.5 g/L + epoxiconazole 62.5 g/L EC | Adexar® | pyrazole-carboximide plus triazole | 1.5 mL | 23.22 ± 0.39 c | 33.22 ± 0.39 c | 8.84 ± 0.76 c |
| Tricyclazole 75% | Force 11TM | melanin biosynthesis inhibitors—reductase | 0.6 g | 8.41 ± 0.80 f | 14.10 ± 0.97 f | 3.56 ± 0.54 f |
| Water (Control) | - | - | - | 66.78 ± 7.04 a | 89.14 ± 4.22 a | 27.98 ± 1.72 a |
| Active Ingredient | Fungicide | Chemical Group | Concentration Per Liter of Water | Yield (Quintal/Hectare) 2018 | Yield (Quintal/Hectare) 2019 |
|---|---|---|---|---|---|
| Flusilazole 12.5% + carbendazim 25% SC | Lustre | triazole plus benzimidazoles | 1 mL | 44.41 ± 3.53 d | 45.73 ± 1.88 e |
| Azoxystrobin 18.2% + difenconazole 11.4% SC | Amistar® Top | triazole plus strobilurin | 1 mL | 63.62 ± 3.20 a | 60.30 ± 2.21 b |
| Azoxystrobin 11% + tebuconazole 18.3% SC | Custodia | triazole plus strobilurin | 1.5 mL | 62.43 ± 3.48 a | 60.29 ± 3.30 b |
| Tricyclazole 18% + mancozeb 62% WP | Merger | triazole plus dithiocarbamate | 2.5 g | 56.09 ± 2.77 b | 54.23 ± 3.18 c |
| Zineb 68% + hexaconazole 4% | Avatar | triazole plus dithiocarbamate | 2.5 g | 51.54 ± 3.35 c | 50.27 ± 2.31 d |
| Trifloxystrobin 25% + tebuconazole 50% WG | Nativo® | triazole plus strobilurin | 0.4 g | 54.50 ± 2.94 b,c | 53.83 ± 2.73 c,d |
| Mancozeb 50% + Carbendazim 25% WS | Sprint® | dithiocarbamate plus benzimidazole | 2.5 g | 41.80 ± 3.15 d | 38.96 ± 3.73 f |
| Fluxapyroxad 62.5 g/L + epoxiconazole 62.5 g/L EC | Adexar® | pyrazole-carboximide plus triazole | 1.5 mL | 41.99 ± 3.53 d | 43.76 ± 2.80 e |
| Tricyclazole 75% | Force 11TM | melanin biosynthesis inhibitors—reductase | 0.6 g | 65.85 ± 3.40 a | 67.73 ± 3.90 a |
| Water (Control) | - | - | - | 31.75 ± 2.50 e | 32.08 ± 3.27 g |
Publisher’s Note: MDPI stays neutral with regard to jurisdictional claims in published maps and institutional affiliations. |
© 2021 by the authors. Licensee MDPI, Basel, Switzerland. This article is an open access article distributed under the terms and conditions of the Creative Commons Attribution (CC BY) license (https://creativecommons.org/licenses/by/4.0/).
Share and Cite
Mohiddin, F.A.; Bhat, N.A.; Wani, S.H.; Bhat, A.H.; Ahanger, M.A.; Shikari, A.B.; Sofi, N.R.; Parveen, S.; Khan, G.H.; Bashir, Z.; et al. Combination of Strobilurin and Triazole Chemicals for the Management of Blast Disease in Mushk Budji -Aromatic Rice. J. Fungi 2021, 7, 1060. https://doi.org/10.3390/jof7121060
Mohiddin FA, Bhat NA, Wani SH, Bhat AH, Ahanger MA, Shikari AB, Sofi NR, Parveen S, Khan GH, Bashir Z, et al. Combination of Strobilurin and Triazole Chemicals for the Management of Blast Disease in Mushk Budji -Aromatic Rice. Journal of Fungi. 2021; 7(12):1060. https://doi.org/10.3390/jof7121060
Chicago/Turabian StyleMohiddin, Fayaz Ahmad, Nazir A. Bhat, Shabir H. Wani, Arif H. Bhat, Mohammad Ashraf Ahanger, Asif B. Shikari, Najeebul Rehman Sofi, Shugufta Parveen, Gazala H. Khan, Zaffar Bashir, and et al. 2021. "Combination of Strobilurin and Triazole Chemicals for the Management of Blast Disease in Mushk Budji -Aromatic Rice" Journal of Fungi 7, no. 12: 1060. https://doi.org/10.3390/jof7121060
APA StyleMohiddin, F. A., Bhat, N. A., Wani, S. H., Bhat, A. H., Ahanger, M. A., Shikari, A. B., Sofi, N. R., Parveen, S., Khan, G. H., Bashir, Z., Vachova, P., Hassan, S., & Sabagh, A. E. (2021). Combination of Strobilurin and Triazole Chemicals for the Management of Blast Disease in Mushk Budji -Aromatic Rice. Journal of Fungi, 7(12), 1060. https://doi.org/10.3390/jof7121060

